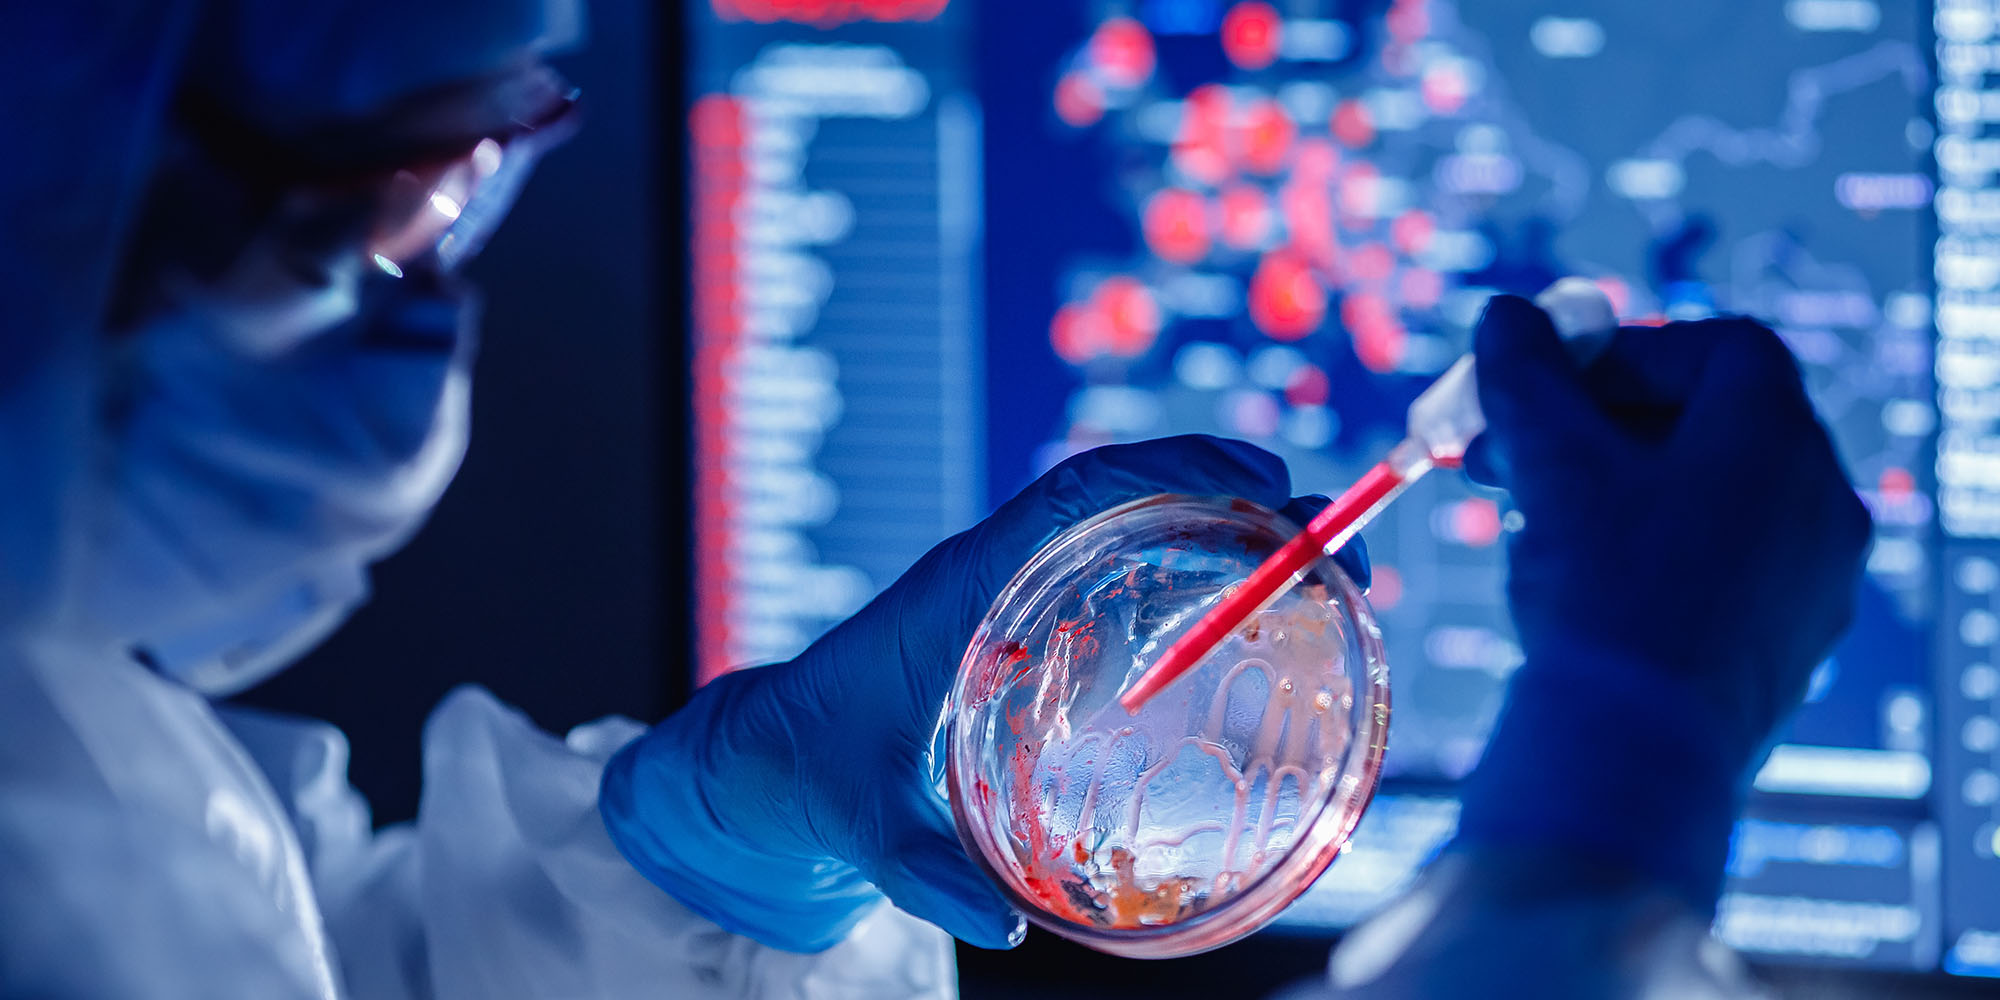
Different types of Covid-19 diagnostic tests get put under the microscope

First published in DM168
Different types of Covid-19 tests are becoming available and it is important to understand which category should be used to ensure your safety.
There are two main ways to test for active infection. Both of them are what we call direct tests, meaning they detect the infectious agent itself – the coronavirus. They are:
- PCR tests and
- The more recently available antigen tests;
We explain them both below.
It is important to understand the difference between direct and indirect tests. Indirect tests pick up antibodies in our blood that are produced when the virus infects our body. These antibodies can be detected in blood samples usually after 14 days, by which time, symptoms of acute Covid-19 have often gone away completely.
What this means is that antibody (also known as ‘serology’) tests are not suited to diagnosing acute Covid-19. Key things you need to know about serology tests are explained in an earlier article by the Scientists Collective: “Testing for Covid-19? All you need to know about antibody tests”.
In this article, we are going to focus on the established PCR test to diagnose acute Covid-19 and a relatively new kid on the block, the antigen test that suggests a person might be infectious.
The main direct test for the coronavirus is a Polymerase Chain Reaction or “PCR”: it is used to identify the viral genetic material in a specimen taken from our upper airways (nasal passage/nostrils or back of the mouth). PCR is a very sensitive technique for detecting the coronavirus, and is also used for other infections common in South Africa: for example, to diagnose HIV infection in babies born to HIV-infected mothers, TB, influenza, Hepatitis B and a host of other viruses that cause the common cold.
Interpreting PCR results – What do positive and negative results really mean?
A negative PCR test result will usually mean that you really don’t have Covid-19 and that if you have symptoms, they are due to something else.
However, it’s important to know that the coronavirus is not present in your airways during part of the incubation period (the time from when the virus infects you to the onset of symptoms).
Therefore, although people who are tested during the very early stage of the infection, when symptoms have not yet developed, will have a negative PCR test result, they may still go on to develop symptoms and become infectious. That is one of the main reasons why people without symptoms should not be tested in the majority of cases. It’s very hard to interpret a negative test result correctly in that setting.
One other reason that the test could be negative, is that it may be what we call a “false negative”. This happens either when the sample taken from your airways is of poor quality thereby reducing the likelihood of detecting the virus in the sample, or the laboratory side goes wrong, eg the PCR reaction itself fails. Quality control measures in the lab will usually reveal this and indicate that a repeat test is needed.
A positive PCR test result means you have acute Covid-19 right now, or have recovered from your symptoms but still have a positive test which is detecting remaining bits of dead virus in your airways.
It’s really important to appreciate that the PCR may be positive for several weeks after your symptoms start, but this does not indicate that you are still infectious because the “load” of the virus decreases with time. PCR only detects the virus’ genetic material, not the whole virus that is needed to infect others. Dead bits of virus genetic material tend to linger, but the “Full Monty” is not there.
Research using other types of tests that can detect “live” infectious virus, tell us that transmission of your coronavirus to others does not happen more than 10 days after your symptoms started. This can be a bit longer for those with severe acute Covid-19 who needed admission to hospital and oxygen support – so in these cases, we consider the risk of transmission to have ended 10 days after oxygen is no longer required. This also explains why requiring a negative PCR test result to allow someone out of isolation or back to work is a waste of time and money – accurately counting days on a calendar suffices for that purpose.
Occasionally “false positive” PCR tests can also happen in the lab, but this is relatively easy to identify through quality control procedures. The fact that countries conducting mass screening of asymptomatic people had very low positivity rates (far below 1%), shows how rare false-positive results are. So you should not worry about this.
Should I have a repeat test if my symptoms continue?
The persistence of clinical illness known as “Long-Covid”, ie symptoms lasting >28 days (see our explainer here) does not seem to be associated with the virus itself sticking around in your airways, so we don’t recommend repeat testing if symptoms persist.
If you have had Covid-19 and recovered, you may have a PCR test again in the future, eg following a high-risk exposure, if you develop symptoms, or for screening prior to travelling abroad.
If this test is positive, does it mean that you have been reinfected? The answer is likely to be no.
Although respiratory viruses, in general, can cause repeat infections quite commonly, and therefore recovering from Covid-19 may likewise not provide good and lasting immunity, our experience in South Africa and globally to date, is that despite there having been more than 50 million cases of Covid-19, reinfection has been rarely reported. Again, judging from our experience with most other respiratory viruses, reinfections generally lead to milder infections in otherwise healthy individuals, the second time around.
Knowing this, what’s the best thing to do in practice?
- First of all, do not test in the absence of a good reason.
See NICD’s advice on who should get tested here. It is possible that this may change in future, in order to balance the demand for testing (which may increase drastically, eg during a future resurgence) and testing capacity.
- Second, do not assume that someone who has had Covid-19 is now immune or non-infectious. For as long as Covid-19 is around it will always be important to practice social distancing, mask-wearing and good hygiene. We simply do not know enough, as we’ve only been learning about the virus for less than a year. It may be that immunity fades quickly, and people can be reinfected as soon as some months or a year after infection. Or immunity may be total and permanent. And dozens of shades between these two.
- Third, should someone who had previously been diagnosed with Covid-19 have a positive test result again, several weeks or months after the first one, the healthcare provider should contact the laboratory and discuss the case. In many cases, a thorough review can rule out reinfection. The advisory and additional guidance document issued by the Ministerial Advisory Committee provide further advice on how to deal with and investigate possible cases of reinfection.
Antigen tests – The new kid on the block
While PCR detects the genetic material of the virus, antigen tests detect one or more specific building blocks of the virus, proteins termed “antigens”.
A positive antigen test tells us that the virus or parts thereof are present in a person, which proves that that person is infected.
Antigen tests are less sophisticated than PCR tests, which makes them easier to perform and cheaper. However, the downside is that they are less sensitive than PCR – ie they are more often negative even when the virus is actually present. Depending on the make of test used, they might also be less specific, which means that when they are positive, the test may be over-calling the presence of the coronavirus, ie a false positive.
Despite these limitations, antigen tests may still be useful in certain scenarios, particularly where speed and simplicity is needed, as they can be designed for rapid use.
For example, rapid antigen testing has recently been introduced to exclude current infectiousness in travellers arriving from abroad who cannot show a negative PCR result taken within the 72 hours prior to travel.
As rapid antigen tests are generally less expensive and less cumbersome to undertake than PCR, they may also play an important role if mass screening is required over a short period of time, eg to investigate outbreaks.
Sometimes they are used prior to people attending a physical event. However, there are ongoing investigations to see how reliable this would be; the recent White House superspreading event happened despite regular rapid antigen testing. This emphasises once again how important it is to choose the appropriate test for a given scenario and to know what it can - and cannot - tell you.
So, in summary:
- If positive, the PCR test is the best way to tell if you have acute Covid-19, or were recently infected by the coronavirus.
- The PCR test can remain positive for weeks. This does not mean that you are infectious or that you still have a live virus, which stops being shed after about 10 days following onset of symptoms, or 10 days after oxygen is no longer needed in hospitalised patients.
- A negative PCR test is more difficult to interpret as false-negative results can occur: If you are symptomatic and have a negative coronavirus PCR, discuss what this means with your healthcare provider.
- Requiring a negative test result to allow someone out of isolation or back to work is a waste of time and money – accurately counting 10 days on a calendar is better and much safer (see our advisory on quarantine and isolation here).
- Antigen testing looks promising, but we are still learning about how best these tests might be used. They might provide the opportunity of doing mass testing, with a rapid turnaround time and are cheaper than PCR, but they are less sensitive than PCR and might thus miss cases.
- Antibody (serology) tests do not tell you if you have acute Covid-19, because symptoms and transmissible virus are usually gone by the time the antibody test is positive. A negative test can falsely reassure you, and a positive one does not necessarily mean you are immune. Serology tests are really only of benefit in mass population studies to give an indication of the percentage of that population that might have been infected. They are of little use to you on a personal level. DM/MC
The Scientists Collective: Prof Wendy Stevens, Prof Marc Mendelson, Prof Francois Venter, Prof Wolfgang Preiser, Prof Shabir Madhi, Prof Glenda Gray
You can get your copy of DM168 at these Pick n Pay stores.

(Photo: Adobe Stock)
(Photo: Adobe Stock)